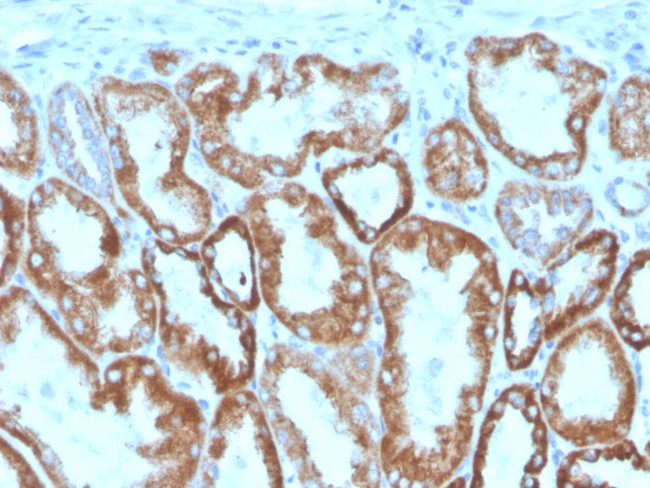
Interferon gamma (IFNG) Antibody in Immunohistochemistry (Paraffin) (IHC (P))

Search
NeoBiotechnologies
Interferon gamma (IFNG) Monoclonal Antibody (IFNG/466), Biotin
{{$productOrderCtrl.translations['antibody.pdp.commerceCard.promotion.promotions']}}
{{$productOrderCtrl.translations['antibody.pdp.commerceCard.promotion.viewpromo']}}
{{$productOrderCtrl.translations['antibody.pdp.commerceCard.promotion.promocode']}}: {{promo.promoCode}} {{promo.promoTitle}} {{promo.promoDescription}}. {{$productOrderCtrl.translations['antibody.pdp.commerceCard.promotion.learnmore']}}
产品信息
3458-MSM4-B1
种属反应
宿主/亚型
分类
类型
克隆号
抗原
偶联物
形式
浓度
规格
纯化类型
保存液
内含物
保存条件
运输条件
靶标信息
IFN gamma (Interferon gamma, Type II interferon) is a macrophage activation factor, and immune interferon that is produced primarily by T-lymphocytes and natural killer cells in response to antigens, mitogens, Staphylococcus enterotoxin B, phytohemaglutanin and other cytokines. IFN gamma is a dimeric protein consisting of two 146 amino acid subunits. IFN gamma is a glycoprotein that exists, functionally, as a homodimer of approximately 45 kDa. On SDS-PAGE, IFN gamma appears as a combination of 25, 20 and minor 15.5 kDa bands as a result of differential glycosylation. The biological activity of the IFN gamma homodimer is highly species specific. Human IFN gamma does not show cross-reactivity with mouse. IFN gamma function includes the following: antiviral activity, tumor antiproliferative activity, induction of class I and II MHC, macrophage activation, and enhanced immunoglobulin secretion by B lymphocytes. IFN gamma is involved in cytokine regulation and also acts synergistically with other cytokines. Activation of IFN gamma takes place through binding of IFN gamma receptor I and II, and activating the JAK-STAT pathway. IFN gamma does not show any homology with IFN alpha or IFN beta but human IFN gamma shows about 40% sequence homology with mouse IFN gamma. IFN gamma is upregulated by IL2, FGF basic, EGF and downregulated by vitamin D3 or DMN. IFN gamma gene mutations are associated with aplastic anemia.
仅用于科研。不用于诊断过程。未经明确授权不得转售。
篇参考文献 (0)
生物信息学
蛋白别名: cytokine; H-IFN-g; IFN γ; IFN-gamma; IFN-y; IFNg; IFNγ; Immune interferon; Interferon; Interferon gamma; Interferon y; Interferon γ; Interferonγ; M-IFN-g; R-IFN-g; unnamed protein product
基因别名: IFG; IFI; IFNG; IMD69
UniProt ID: (Human) P01579
Entrez Gene ID: (Human) 3458